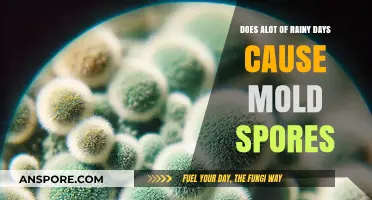
Rainy Days and Mold: Understanding the Connection to Spores

The question of whether an ionizer can effectively kill mold spores is a topic of growing interest, particularly among homeowners and professionals seeking solutions for indoor air quality and mold remediation. Ionizers, also known as air ionizers or negative ion generators, work by emitting negatively charged ions that attach to airborne particles, causing them to become heavier and fall out of the air or stick to surfaces. While ionizers are commonly used to reduce allergens, odors, and particulate matter, their efficacy in eliminating mold spores—which are resilient and can pose health risks—remains a subject of debate. Mold spores are microscopic and can survive in various environments, making them challenging to eradicate. While some studies suggest that ionizers may help reduce airborne mold spore counts by causing them to settle, there is limited evidence to confirm that they directly kill or neutralize mold spores. Therefore, while ionizers may complement mold control strategies, they should not be relied upon as a standalone solution for mold remediation.
| Characteristics | Values |
|---|---|
| Effectiveness on Mold Spores | Limited; ionizers may reduce airborne spores but do not kill mold on surfaces. |
| Mechanism of Action | Releases negatively charged ions to attract and neutralize airborne particles, including mold spores. |
| Surface Mold Treatment | Ineffective; ionizers do not address mold growth on walls, ceilings, or other surfaces. |
| Airborne Spore Reduction | May temporarily reduce airborne mold spore counts but does not eliminate the source. |
| Health Benefits | Potential reduction in allergy or asthma symptoms by decreasing airborne spores. |
| Long-Term Mold Prevention | Not a solution; mold requires moisture control and physical removal for eradication. |
| Energy Consumption | Low to moderate, depending on the device. |
| Maintenance Requirements | Regular cleaning of ionizer plates or filters to maintain efficiency. |
| Cost | Varies; generally affordable compared to professional mold remediation. |
| Environmental Impact | Minimal, as ionizers produce no harmful byproducts. |
| Scientific Consensus | Mixed; some studies suggest limited efficacy, while others show no significant impact on mold spores. |
| Alternative Solutions | Dehumidifiers, HEPA filters, and professional mold removal are more effective. |
Explore related products
What You'll Learn

Ionizer mechanism vs. mold spores
Ionizers, often marketed as air purifiers, operate by emitting negatively charged ions into the air. These ions attach to airborne particles, including mold spores, causing them to become heavier and fall out of the air. While this mechanism effectively removes spores from the breathable atmosphere, it does not inherently kill them. Mold spores are resilient and can remain dormant on surfaces, ready to reactivate under favorable conditions. Thus, ionizers primarily address airborne spore circulation rather than their viability.
To understand the limitations, consider the lifecycle of mold spores. When spores land on surfaces after being weighted down by ions, they are not neutralized. For effective mold control, additional measures such as HEPA filtration or antimicrobial treatments are necessary. Ionizers alone may reduce spore count in the air but do not disrupt the spore’s cellular structure or reproductive capability. This distinction is critical for environments prone to mold, such as damp basements or humid climates.
Practical application of ionizers requires strategic placement and complementary actions. Position the device in areas with high spore concentration, like near windows or vents, and ensure proper ventilation to prevent spore resettlement. Pair ionizers with dehumidifiers to maintain humidity below 50%, as mold thrives in moisture. Regularly clean surfaces where spores accumulate, as ionizers do not prevent spore germination on damp materials. For severe mold issues, consult professionals for remediation.
Comparatively, ionizers differ from methods like UV-C light or chemical treatments, which directly target spore DNA or cell walls. UV-C light, for instance, can render spores inert by damaging their genetic material, but it requires direct exposure. Ionizers, on the other hand, are passive and work continuously without the need for specific positioning or exposure time. However, their effectiveness against mold spores is indirect, making them a supplementary tool rather than a standalone solution.
In conclusion, ionizers offer a mechanism to reduce airborne mold spores but do not kill them. Their utility lies in improving air quality by removing spores from circulation, not in neutralizing their reproductive potential. For comprehensive mold management, combine ionizers with proactive measures like humidity control, surface cleaning, and targeted spore-killing technologies. Understanding this distinction ensures realistic expectations and effective use of ionizers in mold-prone environments.
Are Spores Poisonous or a Disease in D&D 5e?
You may want to see also

Effectiveness of ionizers on airborne spores
Ionizers, often marketed as air purifiers, claim to neutralize airborne particles, including mold spores, by emitting negatively charged ions. These ions attach to particles, causing them to become heavy and fall out of the air, theoretically reducing their presence in breathable spaces. However, the effectiveness of ionizers on airborne mold spores is not universally accepted. While some studies suggest that ionizers can reduce particulate matter in the air, their impact on mold spores specifically remains less clear. Mold spores are resilient and can vary in size, shape, and charge, which complicates their interaction with ionized particles.
To assess effectiveness, consider the mechanism of ionizers. They work by disrupting the electrostatic balance of particles, but mold spores are not uniformly affected due to their biological nature. For instance, smaller spores may be more easily neutralized, while larger, more complex spores might resist the ionization process. Practical application shows that ionizers can reduce airborne spore counts in controlled environments, but real-world settings introduce variables like humidity, airflow, and spore concentration, which can diminish their efficacy. Users should note that ionizers are not a standalone solution for mold remediation but may complement other methods like HEPA filtration.
A comparative analysis reveals that ionizers perform better in enclosed, low-humidity spaces where airflow is minimal. In contrast, high-humidity environments, common in mold-prone areas like basements or bathrooms, can hinder ionizer performance. For optimal results, pair ionizers with dehumidifiers to reduce moisture levels, as mold spores thrive in damp conditions. Additionally, ensure the ionizer is appropriately sized for the space; a small unit in a large room will have negligible impact. Manufacturers often recommend coverage areas, but overestimating needs can yield better results.
Persuasively, while ionizers may not "kill" mold spores outright, they can play a role in managing indoor air quality. Their ability to reduce airborne spore counts can alleviate symptoms for allergy sufferers and prevent spore settlement on surfaces, potentially slowing mold growth. However, reliance on ionizers alone is misguided. Combine their use with regular cleaning, proper ventilation, and moisture control for comprehensive mold management. For severe mold issues, consult professionals who can address the root cause rather than merely treating symptoms.
Instructively, if you decide to use an ionizer, follow these steps: place the unit in a central location with unobstructed airflow, clean the device regularly to prevent particle buildup, and monitor humidity levels to ensure optimal performance. Avoid placing ionizers near electronics, as ozone emissions from some models can damage sensitive components. For households with children, pets, or individuals with respiratory conditions, choose ozone-free ionizers to prevent potential health risks. Lastly, track indoor air quality using spore count tests to gauge the ionizer’s effectiveness over time.
Streptococcus Viridans: Understanding Their Sporulation Capabilities and Implications
You may want to see also

Ionizers vs. mold prevention methods
Ionizers, often marketed as air purifiers, claim to eliminate mold spores by releasing negatively charged ions that attach to airborne particles, causing them to clump together and fall out of the air. While this process can reduce the number of mold spores in the air, it does not inherently kill them. Mold spores are resilient and can remain dormant on surfaces, waiting for favorable conditions to grow. Therefore, relying solely on an ionizer for mold prevention may address airborne spores but leaves surface-dwelling spores untouched, which can lead to recurring mold issues.
In contrast, traditional mold prevention methods focus on controlling moisture, the primary catalyst for mold growth. This includes fixing leaks, using dehumidifiers to maintain indoor humidity below 60%, and ensuring proper ventilation in damp areas like bathrooms and kitchens. These methods directly target the root cause of mold by creating an environment where spores cannot thrive. For instance, running a dehumidifier in a basement can prevent mold growth more effectively than an ionizer, as it eliminates the moisture mold needs to survive.
Combining ionizers with traditional methods can offer a more comprehensive approach. While an ionizer may help reduce airborne spores, it should be paired with moisture control strategies for long-term prevention. For example, using an ionizer in a well-ventilated, dry room can enhance air quality by removing spores that might otherwise settle and grow. However, in high-moisture areas, an ionizer alone will be ineffective without addressing the underlying humidity issue.
Practical tips for integrating these methods include placing ionizers in living spaces where air circulation is limited and using them alongside dehumidifiers in basements or bathrooms. Regularly cleaning or replacing ionizer filters is crucial, as clogged filters can reduce efficiency. Additionally, inspect areas prone to moisture buildup, such as under sinks or around windows, and address any leaks promptly. By combining the air-purifying capabilities of ionizers with proactive moisture management, homeowners can create a more robust defense against mold growth.
Ultimately, while ionizers can play a role in reducing airborne mold spores, they are not a standalone solution for mold prevention. Their effectiveness is maximized when used as part of a broader strategy that includes moisture control, proper ventilation, and regular cleaning. Understanding the limitations of ionizers and pairing them with proven prevention methods ensures a healthier indoor environment and minimizes the risk of mold-related issues.
Exploring Tribal Planet Spore: Capturing Its Essence in Your Gameplay
You may want to see also
Explore related products

Scientific studies on ionizers and mold
Ionizers, often marketed as air purifiers, claim to neutralize mold spores by emitting negatively charged ions that attach to airborne particles, causing them to clump together and fall out of the air. However, scientific studies on their effectiveness against mold spores reveal mixed results. A 2018 study published in the *Journal of Environmental Health Science and Engineering* found that ionizers reduced airborne mold spore counts by up to 40% in controlled environments. Yet, the study also noted that this reduction was temporary and did not address mold growth on surfaces, where spores often originate. This highlights a critical limitation: ionizers may improve air quality momentarily but lack the capability to eradicate mold at its source.
To understand the mechanism, consider how ionizers work. They generate negative ions that bind to positively charged particles like mold spores, theoretically rendering them too heavy to remain airborne. However, this process is highly dependent on environmental factors such as humidity and airflow. A 2020 study in *Indoor Air* demonstrated that ionizers were significantly less effective in high-humidity conditions, where mold thrives. The researchers concluded that while ionizers might reduce airborne spores, they are not a standalone solution for mold remediation. Instead, they should be used in conjunction with dehumidifiers and proper ventilation to address the root causes of mold growth.
Practical application of ionizers requires careful consideration. For instance, in a 2019 study by the *International Journal of Environmental Research and Public Health*, ionizers were tested in residential settings with moderate mold issues. The devices were most effective in small, enclosed spaces with consistent airflow, such as bedrooms. However, in larger areas or spaces with poor ventilation, their impact was negligible. Homeowners should place ionizers strategically, ensuring they are not obstructed by furniture or curtains, and run them continuously for optimal results. It’s also crucial to clean the devices regularly, as dust and debris can reduce their efficiency.
Comparatively, ionizers fall short when measured against proven mold remediation methods like HEPA filtration and chemical treatments. A 2017 comparative study in *Building and Environment* found that HEPA filters removed 99% of airborne mold spores, significantly outperforming ionizers. Additionally, while ionizers are non-toxic and safe for most age groups, their limited efficacy raises questions about their value in severe mold cases. For households with immunocompromised individuals or young children, relying solely on an ionizer could pose health risks by creating a false sense of security.
In conclusion, scientific studies suggest that ionizers can reduce airborne mold spores under specific conditions but are not a comprehensive solution for mold control. Their effectiveness is contingent on factors like room size, humidity, and airflow, making them a supplementary tool rather than a primary intervention. For those considering ionizers, pairing them with dehumidifiers, regular cleaning, and professional mold assessments is essential. While they may improve air quality, addressing mold at its source remains the most effective strategy for long-term prevention.
Blocking with Spore Frog: Can You Sac It Post-Block?
You may want to see also

Limitations of ionizers in mold control
Ionizers, often marketed as air purifiers, claim to neutralize mold spores by emitting negatively charged ions that attach to airborne particles, causing them to clump together and fall out of the air. While this mechanism can reduce airborne mold spores, it does not address the root cause of mold growth or eliminate spores on surfaces. Mold thrives in damp, humid environments, and ionizers do not remove moisture or kill mold colonies directly. This limitation underscores the importance of addressing the underlying conditions that foster mold growth, such as leaks, poor ventilation, or high humidity levels, before relying on ionizers as a solution.
Consider the practical application of ionizers in a mold-prone area, such as a basement. Even if an ionizer successfully reduces airborne spores, mold on walls, floors, or furniture remains unaffected. Mold spores on surfaces can become airborne again through disturbances like cleaning or foot traffic, rendering the ionizer’s temporary effect insufficient. For effective mold control, physical removal of mold through cleaning with EPA-registered fungicides or professional remediation is necessary. Ionizers, at best, serve as a supplementary tool rather than a standalone solution.
Another critical limitation is the variability in ionizer effectiveness based on room size, airflow, and spore concentration. Most ionizers are designed for small to medium-sized spaces, and their impact diminishes in larger areas or rooms with poor air circulation. For example, a 500-square-foot room with moderate mold spore levels may see some improvement, but a 1,500-square-foot basement with high humidity and extensive mold growth will likely show minimal results. Manufacturers often recommend running ionizers continuously, but this can lead to ozone production, a byproduct of ionization that is harmful to humans and pets when present in concentrations above 0.05 ppm.
From a comparative perspective, ionizers fall short when measured against other mold control methods. HEPA air purifiers, for instance, physically trap mold spores and other particles, providing a more reliable reduction in airborne contaminants without producing ozone. Dehumidifiers directly address the moisture that fuels mold growth, making them a more effective preventive measure. While ionizers may offer some benefit in reducing airborne spores, they lack the versatility and comprehensive approach of these alternatives.
In conclusion, while ionizers can play a role in reducing airborne mold spores, their limitations make them an incomplete solution for mold control. They do not kill mold on surfaces, are ineffective in large or poorly ventilated spaces, and pose potential health risks through ozone production. For those dealing with mold, prioritizing moisture control, proper ventilation, and physical removal of mold is essential. Ionizers, if used, should be part of a broader strategy that includes proven methods to address both the symptoms and causes of mold growth.
Injecting Spores into BRF: A Comprehensive Guide for Mushroom Growers
You may want to see also
Frequently asked questions
No, an ionizer does not directly kill mold spores. It works by emitting negatively charged ions that attach to airborne particles, including mold spores, causing them to become heavier and fall out of the air.
An ionizer can help reduce airborne mold spores, which may indirectly prevent mold growth by minimizing spore circulation. However, it does not address existing mold or moisture issues, which are the primary causes of mold growth.
An ionizer is less effective than methods like HEPA filtration, dehumidification, or professional mold removal. It can complement these methods by reducing airborne spores but should not be relied upon as the sole solution for mold problems.
An ionizer may help reduce mold odors by removing airborne particles that contribute to the smell. However, it does not eliminate the source of the odor, which is often the mold itself or the materials it has damaged.
Yes, it is generally safe to use an ionizer in mold-prone areas. However, it should be used alongside other mold prevention strategies, such as controlling humidity and fixing leaks, to effectively manage mold issues.